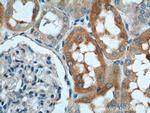
SLC4A1AP Antibody in Immunohistochemistry (Paraffin) (IHC (P))

Search
Proteintech
SLC4A1AP Polyclonal Antibody
{{$productOrderCtrl.translations['antibody.pdp.commerceCard.promotion.promotions']}}
{{$productOrderCtrl.translations['antibody.pdp.commerceCard.promotion.viewpromo']}}
{{$productOrderCtrl.translations['antibody.pdp.commerceCard.promotion.promocode']}}: {{promo.promoCode}} {{promo.promoTitle}} {{promo.promoDescription}}. {{$productOrderCtrl.translations['antibody.pdp.commerceCard.promotion.learnmore']}}
产品信息
21517-1-AP
种属反应
宿主/亚型
分类
类型
抗原
偶联物
形式
浓度
规格
纯化类型
保存液
内含物
保存条件
运输条件
产品详细信息
Immunogen sequence: QLKELRKQQ QILLEKKMLG EDSDEEEEMD TSERKINAGS QDDEMGCTWG MGEDAVEDDA EENPIVLEFQ QEREAFYIKD PKKALQGFFD REGEELEYEF DEQGHSTWLC RVRLPVDDST GKQLVAEAIH SGKKKEAMIQ CSLEACRILD TLGLLRQEAV SRKRKAKNWE DEDFYDSDDD TFLDRTGLIE KKRLNRMKKA GKIDEKPETF ESLVAKLNDA ERELSEISER LKASSQVLSE SPSQDSLDAF MSEMKSGSTL DGVSRKKLHL RTFELRKEQQ RLKGLIKIVK PAEIPELKKT ETQTTGAENK AKKLTLPLFG AMKGGSKFKL KTGTVGKLPP KRPELPPTLM R (291-640 aa encoded by BC099711)
靶标信息
SLC4A1AP gene ontology (GO) annotation includes protein binding and plasma membrane.
仅用于科研。不用于诊断过程。未经明确授权不得转售。
篇参考文献 (0)
生物信息学
蛋白别名: HLC-3; HLC-3 protein; Human lung cancer oncogene 3 protein; Kanadaptin; Kidney anion exchanger adapter protein; kidney anion exchanger adaptor protein; lung cancer oncogene 3; solute carrier family 4 (anion exchanger), member 1, adapter protein; solute carrier family 4 (anion exchanger), member 1, adaptor protein; Solute carrier family 4 anion exchanger member 1 adapter protein; unnamed protein product
基因别名: HLC3; SLC4A1AP
UniProt ID: (Human) Q9BWU0
Entrez Gene ID: (Human) 22950